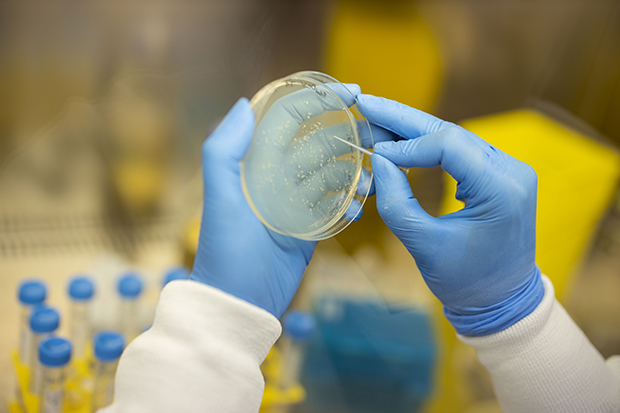

Paving the way for the Coronascam
“The work that had been done over the years on formulations, RNA modifications and other techniques was paying off just in time for the current pandemic. mRNA vaccination was in exactly the right stage for things to take off with a good expectation of success.”

It helps to know how we got here, and the following timeline traces the creation of the DARPA-Big Pharma package of solutions for SARS-CoV-2 and illustrates just how ready they all were. Every outbreak furthered the development of genetic vaccines. Cases were counted according to tests, then compared to deaths ‘associated with’ the virus in question. Every outbreak featured a virus with a cleavage site, and they can all be stabilized with the NIH’s pre-fusion design, just like the corona.
The coronascam solutions were vastly enabled by, i) Baric, Shi and Daszak making bat coronaviruses able to infect humans, and suggesting targets for vaccines, ii) Graham at the VRC developing vaccines, iii) Mclellan, Ward, and others from Dartmouth College and Scripps perfecting the pre-fusion technique, and iv) working closely with Moderna and Curevac to turn it all into mRNA. Plus, of course, a huge amount of money.
All they needed was a pandemic and nothing could have been better than SARS-CoV-2. It’s a virus with an unexplained furin cleavage site that appears to have been made in a lab. It spreads far and wide but without causing chaos. SARS-CoV-2 gets genetic vaccines in by the back door and it kick-starts the Reset. Presumably we’re just lab rats until this phase is over because Gates and Schwab have promised us much worse is to come (apparently a cyber-attack), by which point things’ll be so chaotic, clinical trials will no longer be possible and vax-passports will be mandatory.
Video – Synbioterrorism & the printable pandemic
2000
- Curevac is founded (mRNA potions).
2001
- Methods for producing recombinant coronavirus – patent filed by Baric et al., at the University of North Carolina, Chapel Hill. The coronavirus particles “can be readily targeted to other mucosal surfaces mammalian species such as swine by simple replacements in the S glycoprotein gene, which has been shown to determine tissue and species tropism”, i.e. the particles can be made to infect certain body tissues (e.g. lungs), and even different species of animal, by altering the spike protein (e.g. mutating amino acid residues). The patent acknowledges the danger inherent in this kind of biological material by noting, “the possibility of RNA recombination between the replicon RNA and wild-type virus cannot be eliminated and remains an important issue requiring additional analysis.”
- Operation Dark Winter – simulation of anthrax and smallpox attacks, followed by real anthrax attacks.
2002
- SARS outbreak begins in China. SARS stands for ‘Severe Acute Respiratory Syndrome’ and is said to be a new atypical pneumonia. The virus is said to have jumped from bats to civet cats, and then to humans.
2003
- The WHO announces the end of the SARS outbreak (there were 8,098 cases and 744 deaths).
- Baric works with researchers from U.S. Army Medical Research Institute of Infectious Diseases, Fort Detrick, to make clones of SARS (Urbani strain). The clones are also infectious, which, they claim, “provides a template for manipulation of the viral genome, allowing for the rapid and rational development and testing of candidate vaccines and therapeutics…”
- Since 2003, “there have been six documented SARS disease outbreaks originating from research laboratories, including four in China. These outbreaks caused 13 individual infections and one death.”
2004
- Second Lab Accident Fuels Fears About SARS
- Researchers begin collecting bat coronaviruses to try and find ones like SARS hoping to prove it came from bats.
2005
- Shi and Daszak publish ‘Bats are natural reservoirs of SARS-like coronaviruses’.
- Atlantic Storm, another simulation of a smallpox attack.
- Kariko et al publish the ‘landmark’ paper suggesting mRNA can be made to work if artificial or modified versions are used (such as methylated pseudouridine). She then got funding from the NIH, and the University of Pennsylvania filed patents which were eventually assigned to the NIH.
2006
- The WHO rewrites its International Health Regulations which are binding on all member states (i.e. most of the world!). A Public Health Emergency of International Concern (PHEIC) is defined as an extraordinary event which “constitute[s] a public health risk to other States through international spread of disease and…potentially require[s] a coordinated international response”. Subsequently, a total of six PHEICs were declared: H1N1 (2009), Polio (2014), Ebola (2014 and 2019), Zika (2016) and SARS-CoV-2 (2020).
- The NIH and the EU form the AIDS-CoVAC consortium to create “a novel coronavirus-based HIV vaccine vector that is optimized for host entry”.
- The NIH begin trial of a DNA vaccine for H5N1 (bird flu)
2008
- Baric et al. make some chimeric, synthetic bat-origin SARS coronaviruses that can infect human cells.
- Japanese researchers create a SARS spike protein with a furin cleavage site (like the one that’s strangely appeared in SARS-CoV-2).
- BioNTech is founded (teamed with Pfizer in 2020)
2009
- The WHO changes the definition of a flu pandemic so that deaths and illness are no longer relevant, then declare a swine flu pandemic which lasts until 2010, and is later found to be fake.
- The VRC begin a Phase 1 trial of a DNA-based vaccine for swine flu, just two months after the WHO declare a pandemic. The vaccine was manufactured at the VRC/NIAID/Vaccine Pilot Plant using E. coli bacteria.
- The NIH begins a phase 2 trial of a DNA-based HIV vaccine, called HVTN; (trial is halted in 2013).
- The U.S. Agency for International Development (USAID) initiates a new global emerging pandemic threat program called PREDICT, and it’s based on EcoHealth Alliance’s ‘hotspots’ map.
2010
- Bill and Melinda Gates pledge $10 Billion for ‘the Decade of Vaccines’ (2010-2020)
- Zheng Li Shi et al. publish, “Angiotensin-converting enzyme 2 (ACE2) proteins of different bat species confer variable susceptibility to SARS-CoV entry”
- Moderna is founded – but by who? In September, Derrick Rossi’s paper on mRNA is published and the media narrative, promoted by Rossi, is that this is the research that inspired him to set up Moderna with Tim Springer and Kenneth Chien from Harvard and Robert Langer from MIT. However, he was no expert on mRNA, he appears not to have continued researching mRNA (Rossi’s papers are here), and he’s now disappeared from the founding story altogether. According to Wikipedia, Moderna was founded by Flagship Pioneering/Noubar Afeyan, Springer, Chien and Langer.
- Moderna files patent (‘Engineered nucleic acids and methods of use thereof’)
Video – CDC in collusion with vaccine manufacturers (since 2004 at least!)
2011
- As part of the ADEPT program, DARPA begins investing “in nucleic acid vaccines”. (Moderna, Curevac and Inovio become ‘ADEPT partners’.)
- Curevac teams up with Sanofi Pasteur, and gets $33.1 million as part of a four-year DARPA-supported program
- BioNTech pays for a licence to use modified mRNA
- TranslateBio is founded (mRNA potions).
2012
- Middle East respiratory syndrome (MERS) outbreak begins, and lasts until 2013, with around 2,566 cases and 822 deaths. The virus is said to have jumped from bats to camels, and then to humans.
- Six miners working in the Mojiang mine in China contract a SARS-like illness and three of them die; researchers from WIV (the Wuhan Institute of Virology) go hunting for bat viruses in the Mojiang mine, “on four separate occasions between August 2012 and July 2013”.
- The Global Vaccine Action Plan 2011-2020 is endorsed by the 194 Member States of the World Health Assembly, led by the Bill & Melinda Gates Foundation, GAVI, UNICEF, WHO and the NIH.
- Flagship Ventures secures $40 million funding for Moderna.
- BioNTech start a trial of an RNA-based cancer vaccine (ends in 2015; but details updated 18 January, 2020).
- “Unlike many gene therapies, which could potentially be curative, in Moderna’s case the patient will need to be dosed with the mRNA over and over again. Think ‘recurring revenue stream.’”

2013
- Ebola outbreak – from December 2013 to January 2016, there were 28,616 cases and 11,310 deaths. The Ebola virus is said to have come from bats.
- H7N9 bird flu in China; by March 2014, there are 375 cases and 115 deaths.
- Shi and Daszak publish study on a bat-derived virus that can infect humans (‘Isolation and characterization of a bat SARS-like coronavirus that uses the ACE2 receptor’). They call the virus WIV1. (The ‘parent’ virus is Rs3367), and another virus, RsSHC014.) These viruses are later included in a patent filed by Baric for chimeric coronavirus spike proteins.
- Novavax files a MERS vax patent, which can also be used to create human-like antibodies in transgenic cows or horses, which they tested on people in 2014; side effects include fatigue, loose stools, and sore throat.
- Clinical trials of chimp viruses containing Ebola DNA begin – cAd3-EBO Z developed by NIAID AND GlaxoSmithKline, and EBL01 by University of Oxford, UK. The Wellcome Trust invests $10 million in the Ebola initiative, working with the WHO.
- The 1st International mRNA Health Conference is held in Tübingen, Germany (the place where nucleic acid was discovered by Miescher in 1869 and where Curevac is based!)
- Moderna receives more than $25 million from DARPA and partners with AstraZeneca, who make a large upfront payment of $420 million, and take an 8% share of the company.
- CureVac begin a Phase I trial for mRNA-based rabies vaccine.
- The NIH’s Vaccine Research Centre (VRC) has now tested DNA vaccines containing adenoviruses in 4,697 people and Barney Graham says there’s no need to do ‘aPTT testing’ on them anymore. “aPTT is used to test for coagulation and to detect potential issues with blood clotting due to the presence of antiphospholipid antibodies.” Graham also wants to stop doing heart tests such as ECGs during trials of a different viral vector called modified vaccinia Ankara (MVA).
- Kariko joins BioNTech
2014
- Team Wang develop MERS prefusion design.
- June – 1 June, EcoHealth Alliance (Peter Daszak) receives first round of funding for UNDERSTANDING THE RISK OF BAT CORONAVIRUS EMERGENCE (with $109.7m awarded so far). The research will involve use of infectious clone technology to assess the impact of spike, claiming, “Most emerging human viruses come from wildlife, and these represent a significant threat to public health and biosecurity….”
- October – ‘U.S. Government Gain-of-Function Deliberative Process and Research Funding Pause on Selected Gain-of-Function Research Involving Influenza, MERS, and SARS Viruses’. Work already funded continues regardless.
- Moderna is now valued at around $3 billion; begin partnership with Alexion.
- CureVac is awarded the €2 million Vaccine Prize from the European Commission for their RNActive vaccine platform. Now partnered with Sanofi Pasteur, Curevac publish results of trial for prostate cancer vaccine, and begin trial of mRNA rabies vaccine (ending October 2018).
2015
- WIV researchers, including Zeng Li Shi, publish Bat origin of human coronaviruses.
- Baric, together with researchers from WIV and Chapel Hill, publish, ‘A SARS-like cluster of circulating bat coronaviruses shows potential for human emergence’.
- Baric and Shi publish study comparing the MERS cleavage site to HKU4 bat virus cleavage site to find out which mutations allow it to infect human cells.
- The WHO authorizes large-scale trials of genetic Ebola vaccines in about 27,000 people in Liberia, Sierra Leone, and Guinea.
- Johnson & Johnson’s DNA vaccine for Ebola begins phase 3 clinical trial (ending in June, 2020) with the same Ad26 monkey virus platform they’re using for their coronavirus vaccine. There are 1,023 people in the trial. NCT02509494 (By May of 2020, 60,000 people have received the vaccine.) Funding from NIH and BARDA.
- INOVIO signs a $45 million contract with DARPA, to develop a DNA-based Ebola vaccine. They also get a $28 million grant from the N.I.H. and begin a Phase I clinical trial in Australia.
- The U.N. Sustainable Development Goals now contains 17 goals to be reached by 2030.
- Moderna signs Confidential Disclosure Agreement with NIAID, to develop vaccines for HIV, influenza, Ebola and MERS (signed by Barney Graham from the VRC). Another patent is filed.
- Moderna has now made, “extensive investments in automation” and has “a facility dedicated to making hundreds and thousands of unique mRNA constructs.”
- GamEvac-Combi is licensed in Russia
- The Gates Foundation invests $52 million in CureVac, supporting the construction of a new Good Manufacturing Practice (GMP) production facility; Curevac also secures another $24 million from a private investor.
- A paper is published as part of the CDC’s EPIC CA-Pneumonia Study; for five years, they followed a group of 2,500 people diagnosed with pneumonia, and for 62% of them, “no definitive pathogenic agent was identified.”

2016
- Zika outbreak, with 1,852 cases and 6 deaths.
- Baric’s team at Chapel Hill publish, ‘SARS-like WIV1-CoV poised for human emergence’, acknowledging the dangers of their research, but arguing it’s necessary: “….building new and chimeric reagents must be carefully weighed against potential gain-of-function (GOF) concerns.”
- Shi and Daszak publish ‘Isolation and characterization of a novel bat coronavirus closely related to the direct progenitor of Severe Acute Respiratory Syndrome coronavirus’.
- Inovio gets FDA approval to begin testing its DNA Zika vaccine on humans.
- Moderna signs Research and Development Cooperative Agreement with NIH; agrees a deal with Merck; begins a phase 1 trial of Zika vaccine mRNA-1325 (ending in July 2019), with $125 million from BARDA; publish patent ‘Nucleic Acid Vaccines’. Stéphane Bancel, Chief Executive Officer of Moderna, presents a pipeline update to investors at the 34th Annual J.P. Morgan Healthcare Conference.
2017
- Zika outbreak, with 609 cases and 25 deaths.
- The US funding moratorium on GoF research is lifted.
- DARPA, the Defense Advanced Research Projects Agency, launch the Pandemic Prevention Platform (P3) program and will focus on using DNA and RNA.
- “The Bill and Melinda Gates Foundation this year paid a PR firm called Emerging Ag $1.6 million to recruit a covert coalition of academics to manipulate a UN decision-making process over gene drives, according to emails obtained through Freedom of Information requests…. besides the contribution of the Gates Foundation, most gene drive funding comes from the DARPA.”
- Oxford University publish a MERS vax patent (it uses the same ChAdOx1 adenovirus vector as the AstraZeneca coronavax, and describes how it was tested on 24 human volunteers).
- ID2020 is launched by the UN at the first ID2020 Summit in New York, “in response to the Sustainable Development Goal 16.9: ‘provide legal identity to all, including birth registration, by 2030’” This aligns with the World Bank’s Identification for Development (ID4D) initiative. ID2020’s founding partners include Microsoft, GAVI and the Rockefeller Foundation. They aim to develop a model that provides businesses and governments with “accurate population data” and which could ultimately end up forcing people to use “a portable digital ID”. The ID could begin as an app, and then become a chip in the hand that’s paired with the app. In developing countries, it could be a digital tattoo to confirm vaccine-submission.
- China approves a chimp-virus Ebola-DNA vaccine, co-developed by the Academy of Military Medical Sciences and CanSino Biologics.
- Sanofi and Curevac test the RNActive flu vax using the human MIMIC® system; they reckon it can simulate human immune responses to vaccines, adjuvants, and pathogens. Funding comes from DARPA and In-Cell-Art.
- Kariko and Weissman publish results using mRNA vax for Zika and HIV, supported by Barney Graham from the VRC, and several NIH grants
- ‘Team Prefusion’ publish paper in PNAS, “A rationally designed prefusion MERS-CoV spike antigen”, with the help of millions of dollars in grants from NIH, and use of the Argonne Laboratory, followed by patent (Prefusion Coronavirus Spike Proteins and Their Use WO2018081318A1) filed by The United States Of America on 25 October
- Two months later (23 December) Curevac files a patent for mRNA MERS vax which is stabilized in the prefusion shape with two proline substitutions in the exact same places as the NIH patent (at positions 1060 and 1061)!
- Cellscript/ mRNA RiboTherapeutics sub-license agreement with Moderna for Kariko and Weissman’s modified mRNA invention (e.g. changing uridine to pseudouridine)
- Patisiran (which uses siRNA) is licensed by the FDA.
- Moderna:
- announce results from clinical trials of mRNA therapeutics for diabetes, cardiovascular disease, and cancer, including a heart drug they developed with AstraZeneca.
- scrap their project with Alexion due to bad results in animal trials
- sign a Research Collaboration Agreement with the NIH
- begin clinical trials of several vaccines – mRNA vaccine for H10N8 (completed December 2018), plus mRNA-1325 Zika vaccine (completed December 2019), VAL-339851, an mRNA influenza vaccine (completed January 2021) and cytomegalovirus vaccines mRNA-1647 and mRNA-1443 (also completed January 2021).
- are now worth $5 billion and have 550 employees, including a “bioinformatics team” who come up with new genetic sequences they could try. It’s said there are, “trillions upon trillions of different nucleoside sequences” that can all code for the same protein, so there are lots of new designs to try. Kerching!$!
- Curevac start a clinical trial for a cancer treatment, funded by the Gates Foundation. “CureVac can produce any RNA sequence in a quality fit for medical use within just a few weeks. The same manufacturing process can be used to produce up to seven therapeutic agents in parallel in the same production plant.”
- At the World Economic Forum in Davos, the World Bank and the Gates Foundation host a pandemic simulation, with a focus on vaccines. The launch of CEPI (Coalition for Epidemic Preparedness Innovations) is announced, with funding from the Gates Foundation and the Wellcome Trust.

2018
- Ebola outbreak – from August 2018 to June 2020, there were 3,470 cases and 2,280 deaths.
- Zika outbreak, with 1,800 cases and 4 deaths.
- DARPA launches the PREEMPT program which, “aims to predict and contain viral mutations to prevent cross-species transmission of disease from animals and insects to humans.” Predicting viral mutations involves sampling animals, genetic engineering of novel viruses, animal experiments, and computer modelling, and it’s the kind of work done by Baric, Shi and Daszak.
- A new bat-virus research team is established with scientists from Johns Hopkins, Cornell, Cambridge, UCLA, Penn State, Rocky Mountain Laboratories in Montana, Griffith University in Australia and five other universities and institutions with a $10 million grant from DARPA.
- Daszak and Shi publish Serological Evidence of Bat SARS-Related Coronavirus Infection in Humans, China
- China opens its first BSL-4 lab in Wuhan, with plans to roll out more; US Embassy staff said they had “grave safety concerns” about the lab.
- Inovio and GeneOne Life Science Inc. develop a DNA-based MERS vax (INO-4700), with $56 million from CEPI. (The results were discussed in a ‘Disease Briefing’ for the corona on 30 January, 2020.)
- Mastercard joins forces with ID2020 and Accenture provide a model based on biometrics and blockchain
- At the World Economic Forum meeting in Davos, Gavi announce that digital identity is now part of their 2018 INFUSE program to develop digital child health cards and increase vaccine compliance
- The European Commission wants Member States to “monitor attitudes towards vaccination”, and will develop “a common EU citizens’vaccination card/passport, compatible with electronic immunisation information systems and recognised for use across borders”.
- Pfizer team up with BioNTech to develop mRNA flu vaccines.
- TranslateBio partner with Sanofi Pasteur to develop mRNA vaccines for up to five pathogens.
- NIH grant used to develop MERS-CoV mRNA vaccines that are “suitable for industrial-scale production”.
- Team Prefusion publish ‘Stabilized coronavirus spikes are resistant to conformational changes induced by receptor recognition or proteolysis’.
- The prefusion design that will eventually be used in several coronavirus vaccines is made available for license (‘Collaborative research and licensing opportunity: Prefusion coronavirus spike proteins and their use’ – the promo from the NIH claims it’s better than the natural (wild-type) virus. The patent suggests mutating two amino acids in the spike of a coronavirus to proline, and so they call it S-2P. For SARS, the prolines are to be substituted at positions 968 and 969, and when SARS-CoV-2 arrives, the prolines are placed at positions 986 and 987!
- A few months later, Curevac publish a patent for a mRNA MERS vax which has the exact same proline changes to the spike on MERS. In other words, both the NIH and Curevac patents have proline substitutions at positions 1060 and 1061. (In 2020, Curevac begin using the S-2P design.)
- Moderna begin trial of mRNA-1653 (completed 6 February, 2020) and complete work on a “two-storey, football-pitch-sized manufacturing plant”, costing $130 million. The company is now developing, “multiple commercially meaningful and increasingly complex vaccines”, through their “strategic alliances” with DARPA, BARDA, and Merck.
- Moderna also files patent for RSV vaccine, using a stabilized pre-fusion protein (but not using proline).
- 17 December, the patent for recombinant coronavirus particles, ??? is assigned to the NIH
- The results of the Phase 1/2 trial of Inovio’s DNA plasmid MERS vaccine are reported.
- “CureVac Receives U.S. Patent Covering Entire Process for Pharmaceutical Manufacturing of RNA” and begins phase 1 trial of mRNA rabies vaccine.
- Clade X simulation, based on the concept of a lab-made respiratory virus being unleashed.

2019
- Only 15 Zika cases and no deaths.
- The NIH and the Gates Foundation plan to launch clinical trials and, “develop simpler, affordable ways of delivering genes or gene-editing drugs”.
- An article in ‘Nature’ about mRNA vaccines against rabies and ‘pandemic influenza’ says the “effects waned after less than a year”.
- GAVI wants a scalable child fingerprint identification solution using biometrics to increase vaccination rates in developing countries.
- Russia licenses a viral-vectored Ebola-DNA vaccine
- January to August – US government run the Crimson Contagion pandemic exercise based on the idea that infection with a respiratory virus from China develops into a global pandemic. The results are reported in October.
- February: The Coalition for Epidemic Preparedness Innovations (CEPI) award CureVac $34 million to develop the portable RNA Printer to be ready for Disease X. The three-year partnership between Curevac and CEPI includes a few named organizations, and “an additional technology and engineering partner” (Tesla, presumably). CEO of CureVac, says, “We are excited to be working with CEPI to unlock The RNA Printer’s potential for rapid onsite delivery to outbreak regions, as well as in hospital pharmacy settings for personalized medicine production.”
- July:
- Curevac and Tesla file patent for portable RNA printer
- The US germ warfare lab at Fort Detrick is shut down because of security breaches. Around the same time, people in a nearby nursing home develop a mysterious respiratory illness; 63 residents become ill at Garden Ridge in Greenspring, and 3 of them die, all within the space of two weeks.
- August:
- GSK begin recruiting for a phase 1 trial for their genetic rabies vaccine
- The FDA grants Moderna Fast Track designation for their Zika vaccine (mRNA-1893) and the phase 1 trial begins.
- September:
- Moderna complete the Phase I trial of a chikungunya vaccine, and DARPA release a statement saying, “The researchers have demonstrated that it is feasible to use mRNA sequences to produce and scale a highly potent antibody response against an infectious disease target”.
- BioNTech announce a collaboration with the Gates Foundation, with up to $100 million in funding to develop HIV and TB vaccines using mRNA.
- October (18th – 27th) – Wuhan Military Games take place
- October (the 18th) – Event 201 hosted by World Economic Forum, the Welcome Trust and the Gates Foundation. This time the pandemic simulation is based on a coronavirus.
- November:
- The Fort Detrick lab is partially reopened
- Merck’s DNA-based Ebola vaccine (Ervebo) undergoes, “the fastest vaccine prequalification process ever conducted by WHO”.
- December:
- A phase 1b clinical trial of the MERS ChAdOx1 vax begins
- Ervebo is approved by the FDA;
- Moderna and the NIH agree to transfer their mRNA coronavirus vaccine candidates to Baric at Chapel Hill to perform animal challenge studies
- BioNTech receives 50 million Euro funding from the European Investment Bank.
- By the end of 2019, Moderna had 24 mRNA products in development, with 12 in clinical trials. They’d already tried their mRNA on 1,700 people.
2020
- January, Moderna at the JP Morgan healthcare conference, describe using Amazon’s Cloud Service when designing personalized cancer treatments.
- Bill Gates wants to analyse people’s gut bacteria with ‘organs-on-a-chip’. He also wants to use them to test out new vaccines. “Linking different organ chips together—for example, intestine, liver, and kidney chips—can enable researchers to model human drug kinetics.”
- July, J&J’s DNA-based Ebola vaccine receives a Marketing Authorisation from the European Commission.
- In China, a company called Shanghai Fosun Pharma holds the marketing rights to the Pfizer/BioNTech mRNA vaccine.

2021
- Kernal Biologics, billed as a start-up, sends some mRNA to the International Space Station to test the effects of microgravity.
- DNA Script is partnering with Moderna to a portable DNA printer for, “rapid mobile manufacturing of vaccines and therapeutics as part of the Defense Advanced Research Projects Agency’s (DARPA) Nucleic Acids On-Demand World-Wide (NOW) Program.” The plan is to ‘quickly diagnose pathogen threats’ and “deliver pandemic prevention treatments”. The technology used by DNA Script have also been chosen by, “the Molecular Encoding Consortium and the Intelligence Advanced Research Projects Activity’s (IARPA) Molecular Information Storage (MIST) program to explore nucleic acid data storage.”
- Moderna file patent, ‘Betacoronavirus mRNA vaccine’ – it appears to have been drafted in 2015, and says in the preamble: “Because of a concern for reemergence or a deliberate release of the SARS coronavirus, vaccine development was initiated.”
- AstraZeneca and Johnson & Johnson have said they won’t make a profit during the ‘pandemic phase’, unlike Moderna and Pfizer. “AstraZeneca reserved the right, however, to declare the pandemic phase over and take profits from later vaccine sales.”
yogaesoteric
March 25, 2022